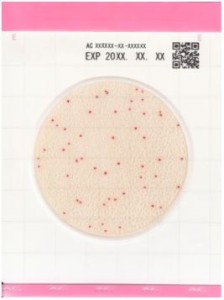
Đĩa Easy Plate AC kiểm tra tổng khuẩn hiếu khí | Kikkoman

Sản phẩm nổi bật
Sản phẩm mới
GIỚI THIỆU CÔNG TY THÁI BÌNH DƯƠNG (PACIFICLAB)
Giới thiệu PacificLAB
Với nhiều năm kinh nghiệm trong lĩnh vực cung cấp thiết bị phòng thí nghiệm, Công ty TNHH Thiết Bị KHKT Thái Bình Dương quy tụ đội ngũ nhân viên được đào tạo chuyên nghiệp, nhiệt tình, có năng lực chuyên môn.
Công ty Thái Bình Dương đang là nhà phân phối chính thức tại Việt Nam của các hãng R-Biopharm, Kikkoman, Shimadzu Diagnostics, Silicycle, Euroclone, Polyskope, Promicol, Nasco Whirl Park, hóa chất tinh khiết Fluka, hóa chất Hydranal, dung môi HPLC của Honeywell, các thiết bị phòng thí nghiệm được ứng dụng cho các nhà máy chế biến thực phẩm, nhà máy dược phẩm, nhà máy thức ăn chăn nuôi, nhà máy sữa, nhà máy chế biến nông sản, nhà máy chế biến thủy sản…
Công ty TNHH Thiết Bị KHKT Thái Bình Dương rất mong được hợp tác với Quý Khách Hàng trong việc cung cấp vật tư tiêu hao, thiết bị và các dịch vụ kèm theo. Với năng lực vững mạnh của Công ty, chúng tôi cam kết sẽ đáp ứng tốt nhất yêu cầu của Quý Khách Hàng.